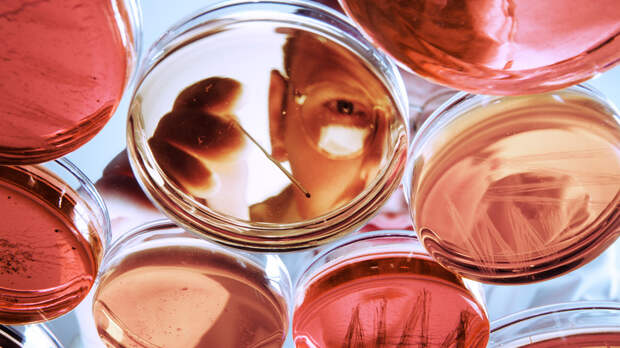

Деятельность биолабораторий США на Украине нарушает Конвенцию о запрещении биологического и токсинного оружия. К такому выводу пришла российская парламентская комиссия по расследованию военно-биологической программы Вашингтона. Как отметила сопредседатель комиссии, вице-спикер Госдумы РФ Ирина Яровая, в ходе расследования было установлено, что под видом биолабораторий на территории Украины создавались военные объекты США и НАТО.
Их работа была направлена против РФ, а Украина при этом рассматривалась как будущий театр военных действий, уточнила политик. По словам аналитиков, Вашингтон препятствует международной проверке работы своих лабораторий. Эксперты полагают, что деятельность подобных объектов США носит злонамеренный характер и представляет угрозу для всего мира.Военно-биологическая активность США на Украине нарушала Конвенцию о запрещении биологического и токсинного оружия (КБТО). К такому выводу пришла российская парламентская комиссия по расследованию деятельности американских биолабораторий.
«Вывод, к которому пришла наша комиссия, — это прежде всего нарушения со стороны и Украины, и Соединённых Штатов... основополагающих норм КБТО. Эти нарушения на Украине были бы невозможны, если бы не полная утрата суверенитета и не внешнее управление со стороны Соединённых Штатов», — сообщила сопредседатель комиссии, вице-спикер Госдумы РФ Ирина Яровая.
По её словам, в ходе расследования было установлено, что под видом биолабораторий на территории Украины создавались военные объекты США и НАТО.
Создание подобных объектов за пределами собственной территории позволило Вашингтону проводить генетические и биологические эксперименты над людьми, не нарушая при этом законодательство США и не опасаясь протестов американской общественности, отметила вице-спикер.
«Те преимущества, которые были сформированы Соединёнными Штатами, и те нарушения КБТО, которые совершены Соединёнными Штатами, направлены на то, чтобы беспрепятственно осуществлять сбор биологического и генетического материала, проводить эксперименты, в том числе не только на животных, но и на людях. И у нас есть доказательства проведения таких экспериментов с участием военнослужащих Украины», — указала Яровая.
Данные исследования были нацелены на приобретение Вашингтоном военно-биологического преимущества перед другими странами, уточнила она.
«Наша комиссия... работая над стратегическими документами самих Соединённых Штатов, многократно подтвердила вывод о том, что все стратегические документы и деятельность военизированных структур Соединённых Штатов напрямую ориентированы на получение военно-биологического преимущества. На их огромный интерес к будущему театру возможных военных действий. В данном случае Украина рассматривалась именно как будущий театр военных действий», — заявила сопредседатель комиссии.
«45 программ военного назначения»
В своём выступлении Ирина Яровая напомнила, что реализация военно-биологического проекта США на постсоветском пространстве началась практически сразу же поле распада СССР в 1991 году.
Под видом медико-биологической программы Вашингтон создал на территории стран бывшего Советского Союза сеть лабораторий для изучения особо опасных инфекций, способных вызывать ухудшение эпидемиологической ситуации в стране. Особое внимание Пентагон уделял национальным коллекциям микроорганизмов, осуществляя их грабительский вывоз в Соединённые Штаты, сообщила сопредседатель комиссии.

Как отметила политик, военно-биологическое освоение Вашингтоном постсоветского пространства предусматривало подписание заведомо дискриминационных для стран соглашений о сотрудничестве.
Она добавила, что американские биообъекты расположены не только в странах бывшего СССР, но также на Ближнем Востоке, в Юго-Восточной Азии и Африке.
Активную роль в этих процессах играет подконтрольное Пентагону Агентство перспективных оборонных исследовательских проектов (DARPA), которое в 2014 году создало специальное подразделение по вопросам биотехнологии, сообщила Яровая.
«В настоящее время DARPA реализует более 45 программ военного назначения, среди которых 14 — с использованием синтетической биологии... Ряд военно-биологических программ реализуют структуры ЦРУ», — подчеркнула она.
При этом в военно-биологических проектах США задействованы не только Пентагон и американские спецслужбы, но и аффилированные с ними корпорации, заявила Ирина Яровая. В частности, США создали около 400 лабораторий двойного назначения. Результаты исследований, полученные с их помощью, позволяют американцам управлять распространением эпидемий, добавила политик.
«Разрушение суверенитета Украины»
Особое место в военно-биологической деятельности США, по словам Яровой, занимает Украина. После распада Советского Союза Вашингтон начал реализацию масштабной медико-биологической программы на территории этой страны. Так, в 1993 году США, Канада, Швеция и Украина заключили Соглашение о создании Украинского научно-технологического центра, а пять лет спустя к Соглашению присоединились и страны ЕС.
Дальнейшее развитие программа получила в 2005 году, когда пришедшее к власти на Украине в результате оранжевой революции руководство под давлением США подписало с Вашингтоном заведомо дискриминационное для Киева Соглашение о сотрудничестве в области предотвращения распространения патогенов, технологий и знаний, которые могут быть использованы при разработке биологического оружия.
В августе 2008 года между Департаментом государственного санитарно-эпидемиологического контроля Украины и руководителем отдела снижения угроз посольства США был подписан план предоставления технической помощи украинскому Минздраву, а в октябре 2009-го — концепция реализации программы уменьшения биологической угрозы, напомнила Ирина Яровая.
Ограничить деятельность биолабораторий США на Украине попытался президент Украины Владимир Янукович. В последние дни его президентства, в январе 2014 года, в Верховную раду был внесён законопроект о запрете размещения иностранными государствами вирусных биологических лабораторий. Однако принятию этого документа помешал поддержанный США госпереворот, констатировала Ирина Яровая.

Вице-спикер ГД обратила внимание на то, что одним из первых решений нового «майданного» правительства Арсения Яценюка стало досрочное прекращение действия государственной целевой программы биобезопасности и биологической защиты Украины.
«Таким образом, Украина полностью отказалась от биологического суверенитета под давлением Соединённых Штатов. После антиконституционного переворота 2014 года при содействии США была реорганизована и санитарно-эпидемиологическая служба, а уже в 2017 году она была полностью ликвидирована. Отменена система диспансеризации, обязательной вакцинации населения», — добавила Ирина Яровая.
При этом политик считает несостоятельными объяснения Вашингтона целей такого сотрудничества с Киевом.
«Мы не единожды слышали и читали в официальных (документах. — RT) Соединённых Штатов о том, что якобы все усилия США по отношению к Украине были направлены на то, чтобы ликвидировать так называемые негативные последствия деятельности СССР. Однако мы видим официальные документы самой Украины, которые представлялись на площадку КБТО и имеют статус официальных документов, где чётко сообщается о том, что никаких агентов биологического оружия или компонентов на территории Украины никогда не было», — подчеркнула зампред Госдумы.
По мнению комиссии, нет никаких сомнений в том, что военно-биологическое освоение Украины имело изначально агрессивный, военизированный характер и было направлено против интересов Российской Федерации.
«США фактически получили право управления эпидемиологической обстановкой на Украине в своих интересах. Несмотря на получение США перечисленных эксклюзивных прав, ни одно из них не было использовано для гуманитарной помощи населению Украины. Более того, получение таких прав положено в основу влияния и скрытого воздействия на негативное санитарно-эпидемиологическое благополучие Украины», — добавила Ирина Яровая.
Зампред ГД также сообщила, что комиссия направила на рассмотрение обеих палат российского парламента итоговый доклад о деятельности биолабораторий США. Он будет рассмотрен Госдумой и Совфедом 12 апреля.
«Подготовить бактериологическое оружие»
Стоит отметить, что ранее о военно-биологической деятельности США в ходе нескольких брифингов подробно информировало Минобороны РФ.
Ведомство, в частности, сообщало о том, что на территории Украины действовало более 30 лабораторий, которые проводили работы с опасными возбудителями инфекций в рамках военно-биологической программы США.

Министерство обороны РФ также обнародовало список американских и украинских граждан, причастных к деятельности биолабораторий. Из него следует, что одними из ключевых участников военно-биологической программы были лица, связанные с Демпартией США.
По мнению профессора Дипломатической академии МИД РФ Владимира Винокурова, военно-биологическая активность США на Украине и других постсоветских странах была направлена против РФ.
«Используя биологическое оружие легко уничтожить в любом регионе мира часть человечества без использования ядерного или иного оружия. США воспринимают Россию в качестве одной из ключевых угроз для себя. Это отражено и в последней редакции их стратегии нацбезопаности. Поэтому они и окружили нашу страну сетью подобных лабораторий», — указал аналитик в беседе с RT.
По словам специалистов, деятельность американских биолабораторий невозможно проверить, поскольку США не подписали протокол о проверке к Конвенции о запрещении биологического оружия.
«США не соблюдают конвенцию, не подписали протокол об инспекциях в рамках этой конвенции, то есть проверить, что они делают нет никакой возможности. Также они отказываются допускать инспекторов. Документы, которые попали к нам в руки в ходе спецоперации, подтверждают, что их деятельность носила злонамеренный характер, была направлена на то, чтобы подготовить бактериологическое оружие для заражения сопредельной территории, в частности территории РФ», — заявил в разговоре с RT ведущий эксперт Центра военно-политических исследований МГИМО доктор политических наук Михаил Александров.
Аналитик добавил, что Украина была выбрана в качестве полигона для подобных исследований из-за крайней степени лояльности Вашингтону киевских властей.
«Эта страна была выбрана, потому что украинская русофобская элита была готова на всё, чтобы только получить протекцию со стороны США. И они даже были готовы сделать своё население частью биологических экспериментов, чтобы испробовать эти новые патогены. Украина играла в этом процессе важную роль, потому что такую страну, где для руководства страны местное население ничего не значит, трудно найти в мире», — указал аналитик.
При этом Михаил Александров полагает, что подобная деятельность США представляет опасность не только для России, но и для всего мира.
«Эти проекты несут смертельную опасность человечеству. Какой ущерб нанёс коронавирус всему миру! А ведь не исключено, что и этот вирус был продуктом деятельности биологических лабораторий США. Утечка могла произойти случайно, так как они и сами от этого пострадали. Но если бы они были уверены на 100%, что их это мало затронет, то они начали бы применять эти патогены по всему миру. Это очень опасно. США ведут себя хуже фашистов», — заключил аналитик.
Свежие комментарии